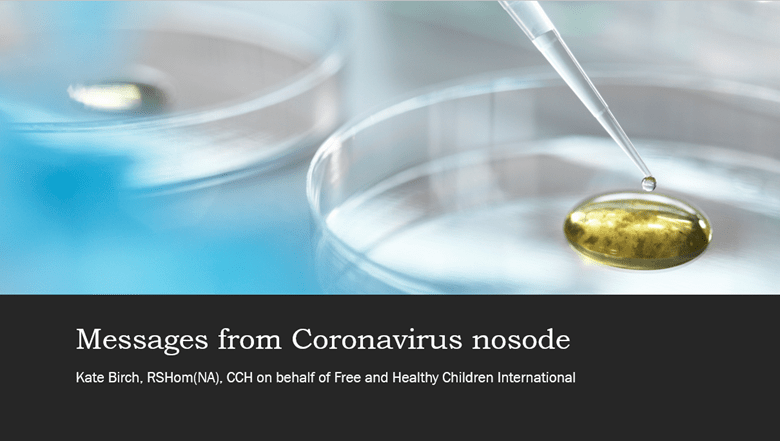

One year after the research closed our work is to be published in June 2021. The research team and HP Supervisor Members have been working with this nosode for the past year with great sucess in clinical practice, for prevention, and treatment of active cases.
This video highlights what we have learned about the transformation humanity is undertaking through this global epidemic. We invite you to come on our journey.
Messages from Coronavirus nosode: Click image to view
Learn more about the research


Hello, Thank you for sharing these presentations! I was hoping to hear the Q&A at the end but that portion was cut off. Is there a link to that portion of your presentation? Thank you for all your work and providing this to the world! We truly are in a moment of transformation on this earth.
Sorry the Q and A section was from a conference. The participants did not give permission for their responses to be recorded and mad e public.